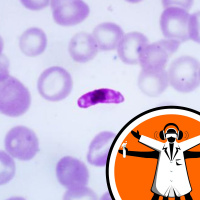
New malaria drug cures with one dose

Synopsis
Probing the weird, wacky and spectacular, the Naked Scientists Special Editions are special one-off scientific reports, investigations and interviews on cutting-edge topics by the Naked Scientists team.
Episodes
-
Schools Causing Covid Surges
10/09/2021 Duration: 05minMost schools across the UK are open and children are heading back to their classrooms. But to what extent will this affect the Covid case rates across the country and what can we do to avoid disrupting a third academic year? In Scotland, children returned to school sooner than their English counterparts: what can we learn from their experience? Chris Smith spoke with Linda Bauld, who specialises in public health at the University of Edinburgh... Like this podcast? Please help us by supporting the Naked Scientists
-
Long COVID in children: what we know so far
09/09/2021 Duration: 05minQuite soon after the pandemic first struck a significant number of people began to complain of persistent symptoms in the aftermath of being infected with the new coronavirus. These manifestations have been dubbed "long covid". What's less clear is the extent to which this is happening not just to adults but also to children, and particularly teenagers. Terence Stephenson is at the UCL Gt Ormond St Institute of Child Health and spoke with Chris Smith... Like this podcast? Please help us by supporting the Naked Scientists
-
Water vapour found on Ganymede
07/09/2021 Duration: 03minWe often look for water on remote planets and moons because, as far as we know, it's a requirement for life. Now a team of researchers using the Hubble Space Telescope to scrutinise Jupiter's largest moon, Ganymede, think they've found water in its atmosphere. Sally Le Page spoke with team member Kurt Retherford. Like this podcast? Please help us by supporting the Naked Scientists
-
What can NZ do about Delta?
21/08/2021 Duration: 20minIs Delta more deadly, or just transmitting more rapidly? And are the vaccines we're using likely to defend against future coronavirus variants? Also, does it matter that levels of antibody dimish post-vaccination, or will immune memory make up for the shortfall? Meanwhile, are vaccinated people who still catch Delta equally infectious? Does Delta incubate at the same rate as classical coronavirus strains? And do tests work equally well against Delta? Like this podcast? Please help us by supporting the Naked Scientists
-
Antibiotic-resistant bacteria in dogs
09/08/2021 Duration: 05minResearchers have reported a case of antibiotic-resistant bacteria passing between dogs and their owners. And these bacteria aren't just resistant to any antibiotic - they're resistant to colistin, an antibiotic of last resort that we use when all other treatments fail. Mark Holmes is a vet and a microbial scientist from the University of Cambridge - he wasn't involved in the research, but he took a look for us and spoke to Eva Higginbotham... Like this podcast? Please help us by supporting the Naked Scientists
-
The UK and Freedom Day: What The Numbers Say
07/08/2021 Duration: 32minChris Smith joins Radio New Zealand National's Kim Hill to talk Covid-19, including the impact of the July 19th UK Freedom Day on Covid case rates. They also touch on vaccine performance, variants, past pandemics and whether we'll all be getting boosters in future years... Like this podcast? Please help us by supporting the Naked Scientists
-
New malaria drug cures with one dose
05/08/2021 Duration: 04minAlthough Covid-19 is dominating the headlines perpetually at the moment, it's very important not to lose sight of other significant diseases that don't yet have vaccines and do have a higher cumulative death toll. Malaria is one of them and kills half a million people, mostly children, every year. One serious problem is that the parasite that causes the disease is rapidly becoming resistant to the remaining antimalarial drugs we're using, so scientists have been searching for new ways to treat the disease. So far, more than 7 million chemical compounds have been screened to try to discover new... Like this podcast? Please help us by supporting the Naked Scientists
-
Increasing likelihood of extreme heatwaves
04/08/2021 Duration: 04minEarlier this year a devastating heatwave in the pacific northwest of the United States killed almost 200 people with record-shattering temperatures; and, in 2019, the UK recorded its highest ever temperature of 38.7 degrees here in Cambridge. Alarmingly, new research from the Swiss Federal Institute of Technology suggests that there's more of this to come. Eva Higginbotham heard why from Erich Fischer... Like this podcast? Please help us by supporting the Naked Scientists
-
Hygiene doesn't harm immune development
14/07/2021 Duration: 06minA question we're being asked quite a lot is whether the extra lengths we're going to in terms of hygiene to protect us from COVID-19 might cause us immune problems later because we're living lives that are too clean. This is the basis of what's dubbed the "hygiene hypothesis". But a report out this week says that, actually, it's the environment we've created - rather than the way we clean it - that matters, because modern living conditions and building materials select for the wrong sorts of microbes. Microbiologist and author of the report, Graham Rook, spoke to Chris Smith... Like this podcast? Please help us by supporting the Naked Scientists
-
Rivers don't always recover after drought
07/07/2021 Duration: 03minThe general view is that waterways, such as rivers and underground water sources, will dry up during severe drought - but eventually recover and resume their normal flow when the rains return. But new findings from Australia pour cold water on that idea. When researchers analysed 30 years of rainfall and flow data from 161 water catchments in southeast Australia, they discovered that one-third of these water catchments had not recovered almost eight years later. Charlotte Birkmanis heard more from Monash University's Tim Peterson... Like this podcast? Please help us by supporting the Naked Scientists
-
'Dragon Man' skull: our closest relative?
06/07/2021 Duration: 04minAn ancient skull, uncovered decades ago in China, has recently been revealed to be possibly the closest ever relative to humankind. It's called "Dragon Man", and based on trace uranium inside the skull, it's been dated to at least 146,000 years old - but could well be much older! This puts it at a critical time period in human evolution, when our ancestors were first emerging within Africa. But there's some disagreement about whether the fossil is from an entirely new species, or is linked to other sets of fossils found in East Asia. Palaeoanthropologist John Hawks, who wasn't involved in the... Like this podcast? Please help us by supporting the Naked Scientists
-
T-rex teens fill mid-size predator gap
05/07/2021 Duration: 04minFew animals inspire the imagination like Tyrannosaurus rex. And the mighty tyrannosaurs did dominate the lands that eventually became central Asia and western North America for millions of years. But during that time, fossils show that medium-sized predators all but disappeared. Why? Thomas Holtz from the University of Maryland dug deep into the records, and - as he tells Charlotte Birkmanis - thinks teen T-rexes are the answer... Like this podcast? Please help us by supporting the Naked Scientists
-
Sharks use Earth's magnetic field as a map
02/07/2021 Duration: 04minPreviously, researchers knew that sharks can travel back and forth across entire oceans, accurately returning to specific locations. But what we didn't know was whether they memorise these routes, or if they have some sort of inbuilt GPS. To find out how sharks navigate, Charlotte Birkmanis mapped the course with Florida State University's Bryan Keller... Like this podcast? Please help us by supporting the Naked Scientists
-
Pesticide antidote might help struggling bees
01/07/2021 Duration: 05minNew technology may help save bees by providing an antidote for deadly pesticides. The new solution allows beekeepers to feed their bees 'pollen patties', a pollen-sized microparticle filled with enzymes to prevent the bees from ingesting certain pesticides. Carlotte Birkmanis chatted with Cornell University's James Webb to get the latest buzz on their sweet technology. Like this podcast? Please help us by supporting the Naked Scientists
-
Covid viruses, vaccines and variants
30/06/2021 Duration: 28minCovid viruses, vaccines and variants: Chris Smith talks to Radio New Zealand National to bring Kim Hill up to speed with the latest developments on the pandemic front, including the recent case in NZ's Wellington... Like this podcast? Please help us by supporting the Naked Scientists
-
Mouse plague in Australia
28/06/2021 Duration: 05minEastern Australia is currently in the grips of a mouse plague. Mice live everywhere people do, often undetected. Right now though, highly favourable conditions have caused mice populations to explode in the eastern states of Queensland and New South Wales. A year of abundant rainfall after several years of drought has led to bumper crops, providing lots of food for mice, allowing them to not only thrive but also reproduce at an astonishing rate. Farmers are using zinc phosphide-coated wheat bait to combat the pests, the only registered in-crop rodent killer for the management of mice in... Like this podcast? Please help us by supporting the Naked Scientists
-
Sperm and squid in space
22/06/2021 Duration: 07minScientists have reported on some unusual things flying in space recently. In one paper, sperm, stored aboard the International Space Station for the last 5 years, has been brought back to Earth and used to fertilise eggs. Also, a group of glow-in-the-dark bobtailed squid headed spacewards to look at how microgravity affects their microbiome. Westminster University astrobiologist Lewis Dartnell talked Chris Smith through the different projects... Like this podcast? Please help us by supporting the Naked Scientists
-
Cells reprogrammed to make synthetic polymers
09/06/2021 Duration: 03minThe world is always on the lookout for new drugs - but they're not easy to make. Synthesising them is often an expensive and prolonged process. But what if we could employ a miniature assistant to do it for us? That's what a team from the MRC Laboratory of Molecular Biology have come up with. They're managed to genetically reprogramme living cells to build complex molecules - molecules that no living thing would ever normally produce. Phil Sansom learned how from researcher Jason Chin... Like this podcast? Please help us by supporting the Naked Scientists
-
Motherless gorillas and how hummingbirds hum
28/05/2021 Duration: 27minThis month: how hummingbirds hum, how elephants evolved anti-cancer genes so they can sustain big bodies, gorillas that grow up without their mothers, and why deforestation causes peaks and then troughs in malaria cases... Like this podcast? Please help us by supporting the Naked Scientists
-
New process may transform mining
27/05/2021 Duration: 04minFor thousands of years, humans have used traditional mining techniques involving sinking tunnels or large pits to recover relatively small amounts of useful metals like gold and copper. What remains is usually, at best, a scar on the landscape, large amounts of waste material, and habitat destruction. At worst, the practices have led to environmental catastrophes. Now an international team, including researchers from the University of Western Australia, have found a way to harness the power of electricity to achieve the same mineral recovery but without the environmental costs. By placing... Like this podcast? Please help us by supporting the Naked Scientists